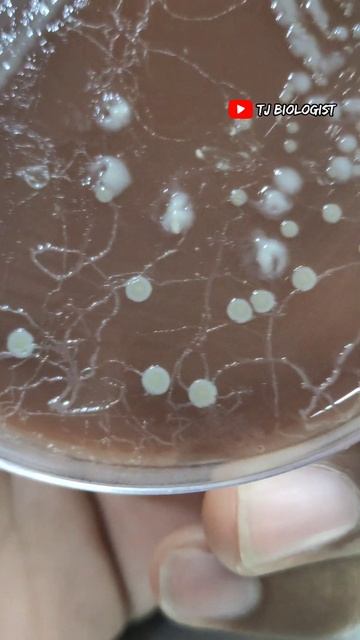
#tjbiologist #science #parasite #animal #trendingshorts #moyemoye #biology #kallakurichi #worms смотреть онлайн

Автор / Канал: Wildlife World Discoveries Страница 8

Rotating LED Ballerina with Musicians Quartet

Snake Fly 2 the creepiest insect I've ever seen

20160220 141332 Макушкин Е ,Палий Д - Симаков Н ,Панченко К

The REAL 2 in 1 Ice Cream Maker by Cra-Z-Art

День 4

Aqua Sun beach

Новое видео про муравьёв! Уборка формикария!

Yakuza Kiwami 2 - Chapter 8: Florist of Sai "Haven't Seen You In A While" Daigo Help Cutscene (2018
#tjbiologist #science #parasite #animal #trendingshorts #moyemoye #biology #kallakurichi #worms

অসহযোগ আন্দোলন ঘিরে দু'পক্ষের সংঘর্ষে ৩ জেলায় ৪ জন নিহত | Country clash death | Jamuna TV
![Lady Frog [ladyfrog] (Arcade Emulated / M.A.M.E.) (207) смотреть онлайн Lady Frog [ladyfrog] (Arcade Emulated / M.A.M.E.) (207) смотреть онлайн](https://pic.rtbcdn.ru/video/2025-02-22/a1/99/a1994c23b405ac5cc21c567859513831.jpg)
Lady Frog [ladyfrog] (Arcade Emulated / M.A.M.E.) (207)

ВЛ80С-642 с грузовым поездом

Dj Tigra- Lights out

NEW 5.56 AK? | Is This The FUTURE of Indian Firearms?

мальчики отрываются в селе.3gp

Umineko no Naku Koro Ni (глава 4) ► Ритуал призыва ► Прохождение #125

Шурик и его отражение)))

ОСТРОВ /5/RAFT прохождение

Nestor

COLLECT 20 SAP | DAILY PURSUIT SERIES | PART 32 | ARK MOBILE | RAPTORS GAMING.

『PURE TRANCE 4』in H.B.TUTENKO

Марселo Лучшие финты и голы,Marcelo Top feints and goals

#ArsipHariIni, 3 Desember 1970. Kunjungan Sri Paulus VI ke Indonesia.

Сайрам
За каждым успешным каналом стоит личность, идея и сотни часов кропотливого труда. Если вы здесь, значит, автор «Wildlife World Discoveries» уже сумел зацепить ваше внимание своим уникальным стилем или подачей. А мы на RUVIDEO позаботились о том, чтобы вы могли изучить весь архив его работ в максимально комфортных условиях — без лишней суеты и преград.
Почему за работами канала «Wildlife World Discoveries» так интересно наблюдать? Всё просто: это честный контент, который находит отклик в сердцах зрителей. На нашем ресурсе вы можете смотреть онлайн все видео любимого автора бесплатно и в хорошем качестве. Нам важно, чтобы вы видели каждую деталь и слышали каждый нюанс, поэтому мы используем только стабильные плееры из открытых источников Rutube.
Следите за новинками канала, пересматривайте старые шедевры и открывайте для себя новые грани творчества «Wildlife World Discoveries». Мы постоянно обновляем ленту, чтобы у вас под рукой всегда были самые свежие выпуски. Никаких сложных регистраций — только вы и творчество, которое вдохновляет. Приятного вам путешествия по миру авторского контента на RUVIDEO!
Видео взято из открытых источников Rutube. Если вы правообладатель, обратитесь к первоисточнику.